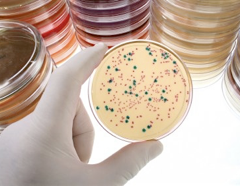
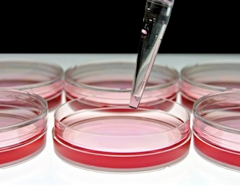

Pipeline
RetroVirox is building a proprietary product pipeline of novel small-molecules with antiviral and immunomodulatory properties.
HIV Immunomodulators for HIV Eradication
Over 35 million people worldwide are infected with HIV. Patients can be successfully treated with antiretroviral cocktails that achieve viral load reductions below levels of detection. However, infected individuals also carry in their genome copies of the HIV provirus in a state of latency. In this form, HIV can hide for decades within cells and tissues named “viral reservoirs”, where the virus remains virtually invisible to the patient’s immune system.
Due to the HIV’s ability to remain dormant, antiretroviral therapy must be administered throughout the patient’s lifetime. Treatment interruption results in rebound of the viral load, which often leads to the appearance of resistant strains that further complicate therapy. RetroVirox is developing immunomodulators as components of “kick and kill” strategies to eradicate HIV. In these approaches the dormant virus is first purged away from the viral reservoirs by activating latently-infected cells to produce viruses. The killing of these reactivated cells is then facilitated with small-molecules that enhance the ability of the immune system to recognize HIV antigens.